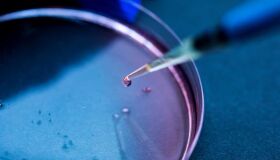
Embriões híbridos: a ciência pode tudo?

- 21 Jun 202506h00min

Filhos em série: os perigos da reprodução assistida sem controle
- 07 Jun 202506h00min

Saúde à venda: o lucro acima da ciência e da ética
- 17 Mai 202506h00min

Robôs no hospital: inovação ou ameaça à humanidade no cuidado com a saúde?
- 03 Mai 202506h00min

Direito à saúde e trabalho: um olhar necessário
- 19 Abr 202506h00min

Novas regras para aquisição de canetas para emagrecer: proteção à saúde pública e uso responsável
Medida da Anvisa regulamenta venda desses medicamentos, exigindo receita médica nas farmácias
- 05 Abr 202506h01min

Semana Nacional da Saúde
- 22 Mar 202506h00min

Saúde mental das mulheres: desafios invisíveis, urgências reais
- 22 Fev 202506h00min
A proposta da ANS para planos de saúde mais baratos: o que está em jogo?
- 08 Fev 202506h00min

Cancelamento do plano de saúde por inadimplência
Novas regras definidas pela ANS entraram em vigor desde 1º de fevereiro de 2025
- 25 Jan 202506h00min
Embriões híbridos: a ciência pode tudo?







